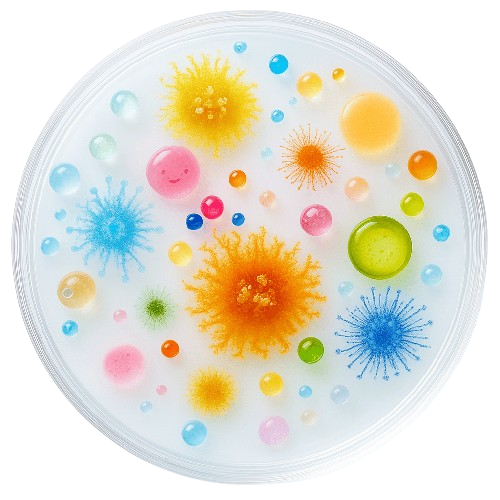

Hace más de 15 años comenzamos este camino con un objetivo claro: brindar análisis confiables que ayuden a cuidar la salud y la calidad de vida de las personas y animales.
Somos un laboratorio especializado en análisis de aguas y alimentos dirigido por profesionales microbiólogos, con base en Venado Tuerto . A lo largo de los años fuimos creciendo, incorporando tecnología, capacitándonos y mejorando nuestros procesos, siempre avanzando enfocados en la calidad de nuestros resultados y la necesidad de cada cliente.
Nos apasiona lo que hacemos! Sabemos que detrás de cada muestra hay una familia, una empresa o una comunidad que necesita soluciones confiables, rápidas y precisas, es por ello que en Laboratorios Biosred combinamos nuestra atencion personalizada, experiencia y calidad en cada resultado.
Utilizo los servicios de análisis para controlar periódicamente la calidad del agua que consumimos en mi casa. Estoy muy conforme con la claridad de los reportes, el tiempo de entrega de los mismos, y sobre todo con la predisposición de Julieta en todo momento. Gracias!
Estoy muy conforme con el trabajo realizado por Laboratorio Biosred en los análisis de aguas y alimentos para mi empresa y mis clientes. La atención es ágil y profesional, que se adapta a lo que necesito, con un seguimiento constante durante todo el proceso. Los informes son claros, detallados y entregados en los tiempos acordados, lo que nos permitió cumplir con los requisitos que teníamos sin demoras. Es un servicio confiable que sin dudas volveremos a contratar.
Nuestra experiencia con el laboratorio fue muy recomendable. Resolvieron todas nuestras dudas con claridad y paciencia. Además, fueron muy atentos durante todo el proceso, manteniéndonos informados y cumpliendo con los plazos acordados. Sin duda volveremos a elegirlos.
Quería destacar la atención que recibí de Laboratorio Biosred por análisis de aguas biológicas y físico químicas....muy bien... gracias!
Llevamos a hacer análisis de agua, excelente atención, muy profesional todo el trabajo previo, nos explicó como tomar las muestras, y la devolución luego sobre la calidad del agua fue muy clara.

Nuestra trayectoria nos ha permitido brindar soluciones a clientes unipersonales como así también a pymes y grandes empresas multinacionales con quienes hemos desarrollado diseños experimentales innovadores, implementado rigurosos procesos de control y brindado asesoramiento en cada momento

Implementamos rigurosos protocolos de análisis para asegurar la máxima precisión y confiabilidad en cada resultado
© 2025. Todos los derechos reservados.